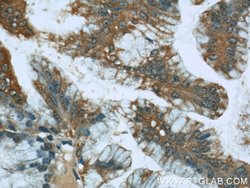
STIM1 Rabbit anti-Human, Mouse, Polyclonal, Proteintech 150 &mu;L; Unconjugated:Anticuerpos

Learn More
STIM1 Rabbit anti-Human, Mouse, Polyclonal, Proteintech
Rabbit Polyclonal Antibody
Marca: Proteintech 11565-1-AP-150UL
Descripción
The MW of STIM1 is about 80-90 kDa which may be due to the phosphorylation or glycosylation forms. 11565-1-AP is rabbit polyclonal antibody raised against the N-terminal of human STIM1.
This gene encodes a type 1 transmembrane protein that mediates Ca2+ influx after depletion of intracellular Ca2+ stores by gating of store-operated Ca2+ influx channels (SOCs). It is one of several genes located in the imprinted gene domain of 11p15.5, an important tumor-suppressor gene region. Alterations in this region have been associated with the Beckwith-Wiedemann syndrome, Wilms tumor, rhabdomyosarcoma, adrenocrotical carcinoma, and lung, ovarian, and breast cancer. This gene may play a role in maligcies and disease that involve this region, as well as early hematopoiesis, by mediating attachment to stromal cells. This gene is oriented in a head-to-tail configuration with the ribonucleotide reductase 1 gene (RRM1), with the 3′ end of this gene situated 1.6 kb from the 5′ end of the RRM1 gene.Especificaciones
| STIM1 | |
| Polyclonal | |
| Unconjugated | |
| STIM1 | |
| D11S4896E, GOK, STIM1, stromal interaction molecule 1 | |
| Rabbit | |
| Antigen Affinity Chromatography | |
| RUO | |
| 20866, 6786 | |
| -20°C | |
| Liquid |
| Flow Cytometry, Immunocytochemistry, Immunofluorescence, Immunohistochemistry (Paraffin), Immunoprecipitation | |
| 0.42 mg/mL | |
| PBS with 50% glycerol and 0.1% sodium azide; pH 7.3 | |
| P70302, Q13586 | |
| STIM1 | |
| STIM1 Fusion Protein Ag2140 | |
| 150 μL | |
| Primary | |
| Human, Mouse | |
| Antibody | |
| IgG |
Al hacer clic en Enviar, acepta que Fisher Scientific se ponga en contacto con usted en relación con los comentarios que ha proporcionado en este formulario. No compartiremos su información para ningún otro fin. Toda la información de contacto proporcionada se mantendrá de acuerdo con nuestra Política de Privacidad. Política de privacidad.